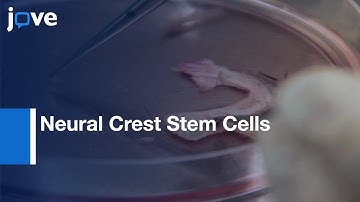
Isolation & Culture: Neural Crest Stem Cells From Human Hair Follicles l Protocol Preview

⬇ DOWNLOAD NOW
Kalau muncul iklan pop-up, tutup lalu klik tombol kembali
Download lagu Neural Crest Progenitor Cells derived from hPSCs | Protocol Preview secara gratis hanya untuk keperluan promosi. Dukung artis favorit kamu dengan membeli musik original di iTunes atau platform resmi lainnya.
 How to Generate Neural Progenitor Cells from hPSCs Using STEMdiff™ Neural Induction Medium
How to Generate Neural Progenitor Cells from hPSCs Using STEMdiff™ Neural Induction Medium
 Neural Crest Cells and Blood Vessels dual Labelling | Protocol Preview
Neural Crest Cells and Blood Vessels dual Labelling | Protocol Preview
Isolation & Culture: Neural Crest Stem Cells From Human Hair Follicles l Protocol Preview
Isolation & Culture: Neural Crest Stem Cells From Human Hair Follicles l Protocol Preview
 Neural Crest Cells Migration Visualization by Multi-Photon Imaging | Protocol Preview
Neural Crest Cells Migration Visualization by Multi-Photon Imaging | Protocol Preview
 Expandable Neural Progenitor Cells generated from derived Fibroblasts | Protocol Preview
Expandable Neural Progenitor Cells generated from derived Fibroblasts | Protocol Preview
 O9-1 Neural Crest Cells Manipulaton and Culturing | Protocol Preview
O9-1 Neural Crest Cells Manipulaton and Culturing | Protocol Preview
 Analysis: Neural Crest Migration & Differentiation l Protocol Preview
Analysis: Neural Crest Migration & Differentiation l Protocol Preview
 hiPSC Derived NPCs for the Study of Neurological Diseases | Protocol Preview
hiPSC Derived NPCs for the Study of Neurological Diseases | Protocol Preview